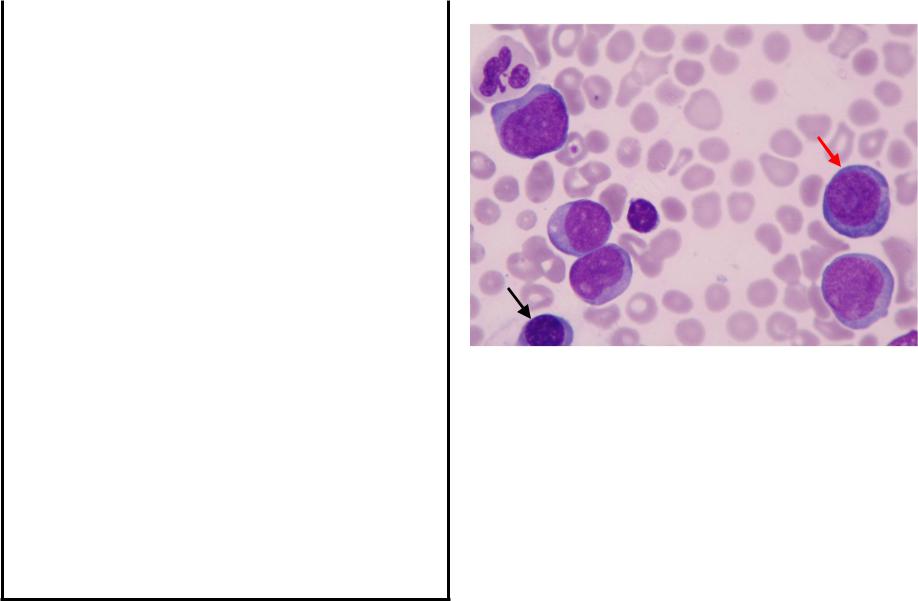

Материал: клинический+анализ+крови+3

ОЛЛ Цитохимическое и иммуноцитохимическое исследование бластов
CD 10 – иммуно-
цитохимическое исследование на common рецептор, наличие которого свидетельствует о ОЛЛ В2
Реакция на пероксидазу в лимфобластах отрицательна, в нейтрофилах – положительна
Острый миелоидный лейкоз (ОМЛ)
Гемоглобин, г/л |
60 |
|
|
Эритроциты, х1012/л |
2,01 |
Цветовой показатель |
0,9 |
|
|
Ретикулоциты, % |
0,5 |
|
|
Лейкоциты, 109/л |
22,6 |
Миелобласты, % |
67 |
|
|
Промиелоциты, % |
|
|
|
Миелоциты, % |
|
|
|
Палочкоядерные |
3 |
|
|
Сегментоядерные |
23 |
|
|
Эозинофилы |
|
|
|
Базофилы, % |
|
|
|
Лимфобласты |
|
|
|
Лимфоциты |
2 |
|
|
Моноциты, % |
5 |
|
|
Тромбоциты, 109/л |
23 |
СОЭ, мм/час |
41 |
|
|
Дополнительные сведения. В бластах: POX 76%, PAS – реакция диффузная, в 42%
Окраска по Романовскому-Гимзе. Четыре миелобласта, нейтрофил, лимфоцит, эритробласт (красная стрелка) и полихроматофильный эритрокариоцит (чёрная стрелка).
Миелобластный лейкоз (ОМЛ)
Критерии диагноза
Острый миелоидный лейкоз
диагностируется при наличии
• в крови бластов 20% и более
или
• в миелограммебластов 20% и более
При количестве бластов менее 20% диагностируется
миелодиспластический синдром (МДС), за исключением (см.след.слайд)
Острый миелоидный лейкоз
Критерии диагноза
Исключение:
•при типичных хромосомных аномалиях
– t(8;21), inv(16) или t(16;16), t(15;17),
аномалия 11q23
•при М5в (промоноцитарный ОМЛ)
для диагностики ОМЛ процент бластов не имеет значения

ОМЛ Цитологическое и цитохимическое исследование мазков костного мозга
Палочки Ауэра в |
Миелопероксидаза |
миелобластах |
в миелобластах |
|